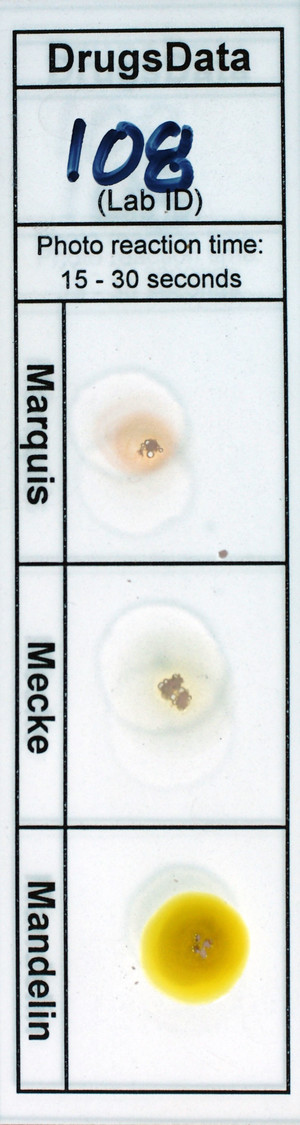
Detail Photo

New Submissions Are Not Currently Being Accepted
Samples sent after April 10, 2024 will be put on hold.
Viewing desktop version: Switch to Mobile
Cocaine
Sold as: Cocaine
ID: 9887
Sold as: Cocaine
Expected to be: Cocaine

It's important that samples submitted to this testing program be no more than 200 mg of material (ideally 20 to 50 mg). Keep in mind that just enough to *half* fill a capsule is more than enough. There is no advantage to sending more material, and samples that are too heavy may be delayed or require additional payment.
See how to send in a sample for testing.
We always report active adulterants and diluents (cuts) like phenacetin and tetramisole/levamisole. Inert diluents like sugars, sodium bicarbonate, etc. can not be reported even if they might be present. This means 'purity' can't be confirmed, either.